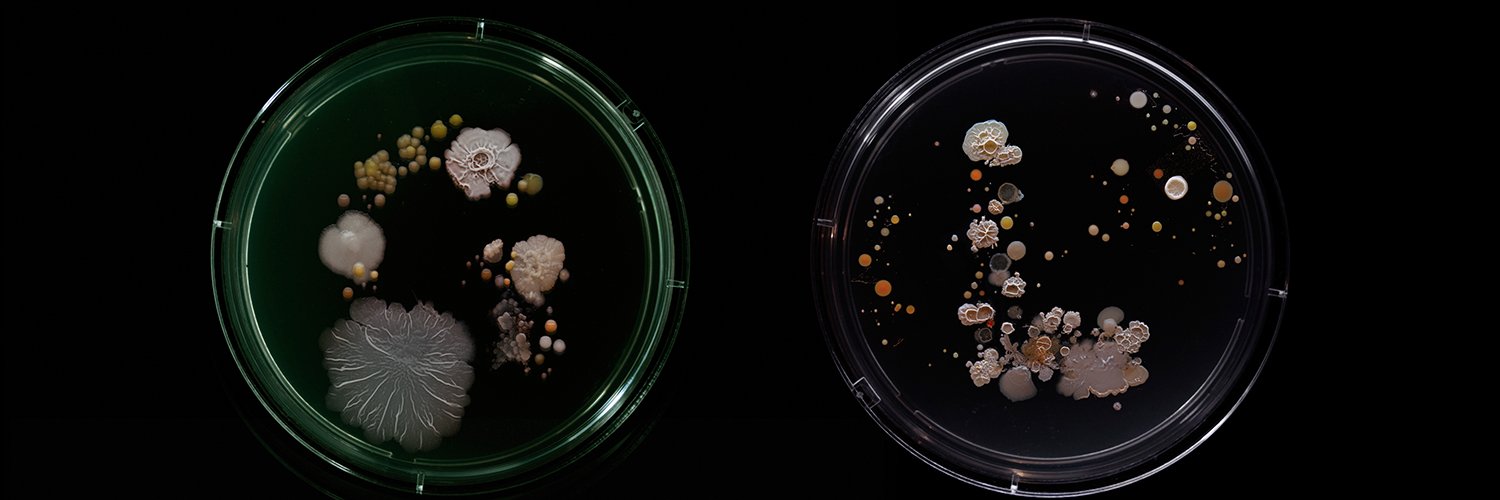
Scott Quainoo banner

Sabitlenmiş Tweet
Scott Quainoo
1.2K posts

Scott Quainoo
@sq_microbio
CEO @UnveilBio, all things #microbiome #synbio #nextgenseq ☣️🖥️📊💯
Katılım Nisan 2016
317 Takip Edilen665 Takipçiler
Scott Quainoo retweetledi

A shocking study published by the folks at @VectorBuilder:
45-50% of lab-made plasmids have undetected design and/or sequence errors!
Talk about the importance of Whole Plasmid Sequencing!
Visit eu1.hubs.ly/H0b8yPz0 to learn more.
eu1.hubs.ly/H0b8zl_0

English
Scott Quainoo retweetledi
Scott Quainoo retweetledi

Our foundation is built on deep expertise & nearly a decade of experience with @oxfordnanopore . Our co-founder & CEO @sq_microbio , saw the potential of Whole Plasmid Sequencing early on, envisioning its impact beyond routine plasmid validation to industrial applications. (1/7)

English
Scott Quainoo retweetledi
Scott Quainoo retweetledi

A detailed analysis report is useless if it's difficult to understand.
We've heard your feedback. To make it easier for you to judge the quality of your plasmid assemblies, we've created a walkthrough video of our Quality Report: eu1.hubs.ly/H06_QTH0
#WholePlasmidSequencing
English
Scott Quainoo retweetledi
Scott Quainoo retweetledi

Thinking about the best way to use your remaining budget or grant?
Consider gearing up for next year's research with Unveil Bio's pre-paid credits. Streamline your Whole Plasmid Sequencing orders & avoid repetitive card payments. Contact us at support@unveil.bio and learn more.
English
Scott Quainoo retweetledi

So, how does it work❓❓❓
We've introduced ourselves, now it's time to show you how it all works.
Check out our submission guide for more details and see how easy it is to get started with Unveil Bio: eu1.hubs.ly/H06wc0D0
#DiscoverTheUnknown #NGS #genomics #biotechnology
English
Scott Quainoo retweetledi

We are thrilled to announce that we have been selected for the prestigious Innofounder program by Innovationsfonden!
The program will accelerate our growth with mentorship, funding, & access to a network of partners & investors.
#DiscoverTheUnknown #NGS #genomics #biotechnology
English
Scott Quainoo retweetledi
Scott Quainoo retweetledi

20 years of genomics! How many can you identify? #fcgz @ETH_en @UZH_Science (not complete, we are still looking through all our drawers)
English
Scott Quainoo retweetledi

The culmination of 10+ years of work to use #CRISPR gene editing to fight heart disease!
@ambellinger @VerveTx $VERV presenting the interim data from the ongoing heart-1 Phase 1b clinical trial of VERVE-101 base editing for HeFH patients, at #AHA23 now.
Let’s start!
🧵

Kiran Musunuru@kiranmusunuru
How to use #CRISPR gene editing to fight heart disease, the #1 killer worldwide: A thread 10+ years in the making. This one starts in 2009 when I was a postdoc in @skathire lab @MassGeneralNews/@broadinstitute studying ❤ risk factors like cholesterol & triglycerides. (thread)
English
Scott Quainoo retweetledi
Scott Quainoo retweetledi

We have exciting news! Northern Nanopore has been acquired by Oxford Nanopore Technologies! Read the press release here: nanoporetech.com/about-us/news/… @nanopore

English
Scott Quainoo retweetledi

I am humbled and honoured to receive the Silver Medal for excellent basic research from @VSelskab (The Royal Danish Academy of Science and Letters) for my work on #snakebite #antivenoms and my bioentrepreneurial activities!
@DTUtweet @DTUbioengineer
Kongelige Danske Videnskabernes Selskab@VSelskab
STORT tillykke til professor, centerleder og biotek-entreprenør fra DTU Andreas Hougaard Laustsen-Kiel, som i dag modtager @VSelskabs Sølvmedalje og prislegat på 100.000 kr. Læs om Andreas' forskning i slangegift og hans enorme entreprenørskab på royalacademy.dk #dkforsk
English
Scott Quainoo retweetledi
Scott Quainoo retweetledi

Remember when reading both strands of the DNA with @nanopore would give you 85 % identity hits? Here is a 100+ kbp 5khz duplex read from the zymo HMW mock with 99.98 % identity 🥳
(Wonder for how long the high error rate ghost will haunt the literature)


English









